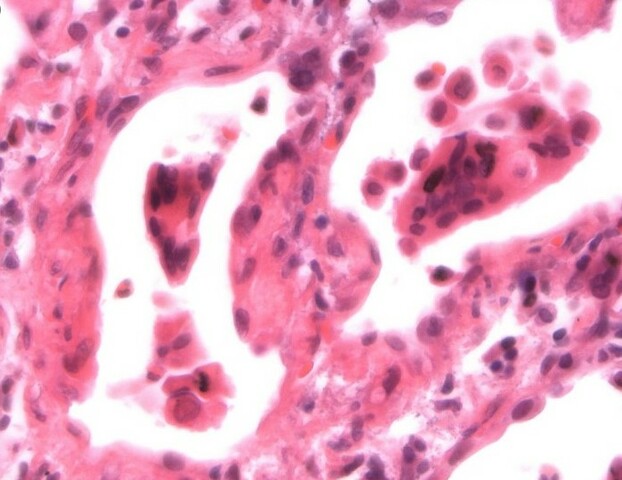
Oswald Avery,  Maclyn McCarty & Colin McCleod

-
Miescher extracted DNA from the cell nuclei, he determined that DNA is not a protein and is rich in nitrogen and phosphorus. But he did not ever get the chance to learn the function of DNA. The picture depicts the process of removing the DNA from the nuclei.
-
He was studying pneumonia-causing bacteria where he isolated two strands in which he experimented on them where he discovered that heat destroyed the lethal strands bacteria to form pneumonia. One interesting thing that he discovered is that one dead lethal strand can transfer this material to the harmless strand. The picture shows the rats that were injected with the bacteria that Griffith used to discover the different types of strands.
-
McClintock was able to discover mobile genetic elements while studying the genetic mutations involved in corn and corn chromosomes using microscopes. The discovered genetic elements ended up being genes that could jump from chromosomes to different chromosomes. The picture shows the corn that Barbara used to discover the genetic elements.
-
They used Griffith's information on this “transforming principle”, they extracted a protein, a lipid, and nucleic acids from this lethal strand. They realized that the substance must be a nucleic acid, meaning RNA or DNA, but DNA gets rid of its ability to transform enzymes while RNA does not. This means DNA has to be the nucleic acid used. This picture represents a pneumonia cell like one of the ones used in theis experiments, the lethal cell.
-
Chargaff discovered that the amounts of adenine and thymine, as well as guanine and cytosine are equal in cells. He also discovered that the DNA differs in between species because of the proportions of adenine and guanine. Chargaff was one of the scientists that studied the DNA function. The picture depicts the bond that Chargaff discovered that connects Adenine and Thymine.
-
Hershey and Chase proved that DNA satisfies properties of hereditary material. They proved this by using a virus that infects bacteria and injected it into bacteria, the result of this is the virus being a form of DNA rather than a protein. One interesting thing about them is these transmit a full complement of hereditary information. The picture shows how Hershey injected the bacteria with the virus.
-
Franklin and Wilkins studied the structure of DNA, Franklin specialized in x-ray crystallography. The atoms in the DNA were scattered by the x-ray forming the ability to be captured in an image. They use this pattern to depict the size, shape, and structure of DNA. The picture shows the two different kinds of DNA franklin discovered using x-ray crystallography.
-
Watson and Crick tried to discover the structure of DNA, they discovered the coiled structure of proteins in DNA represented as a helix. They made models of scrap metal connected by bonds represented as wires. the picture shows a digital depiction of the model that Watson and Crick created resembling the double helix of DNA.
-
Linus Pauling used his research on sickle cell anemia to make his discovery of the spiral structure of DNA proteins. He was the one who proposed the triple helix model which was then found wrong in the future. The triple helix was later corrected by Watson and Crick with the double helix.The picture shows the triple helix that linus pauling came up with as a structure of DNA.
-
Meselson and Stahl came to find DNA replicants that were then labeled old DNA and new DNA. They conducted their experiments using E.coli bacteria as a model system for their DNA replication. This resulted in four different types of E. coli to be formed which were labeled generation 0, generation 1, generation 2, and generation 3. The picture shows th different generations of growth as well as the different E. coli generations that were discovered.
-
Sanger was able to create a protein sequence proving that proteins were in order from studying insulin and the order of amino groups. This since proved that genes and DNA are ordered, he also studied the methods of arranging RNA where he created a method that uses DNA sequencing. The picture represents Sanger's method of DNA sequencing.
-
Berg decided to study a tumor virus which allowed Berg to place DNA from bacteria into the tumor's virus DNA. This created the first molecule that had two different species DNA. The picture is representativ of the different pieces of DNA being combined together to form the first DNA strand made from different organisms.
-
Mullis invented ways of copying specific portions of DNA in a short period of time. He figured this out by heating ingredients with DNA in them, this caused the DNA template to separate. This allowed the polymerase enzyme to add nucleotides to the primers. This allowed for over a billion duplicates to be made in only a few minutes.The picture of yellowstone is supposed to represent Mullis' experiment in which he heat up the DNA causing the template to breakdown.
-
sing the shotgun technique, Venter was the first person to sequence the human genome. This deciphered small portions of genomic sequence, this would be then put together to create a whole genomic sequence. The picture shows geonomic sequencing through the shotgun method.
A list shows items. A timeline shows sequence.
Use Timetoast to make dates, milestones, and turning points easier to understand in a clear visual format. Timetoast is a timeline maker for work, school, research, and stories.